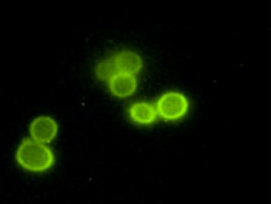
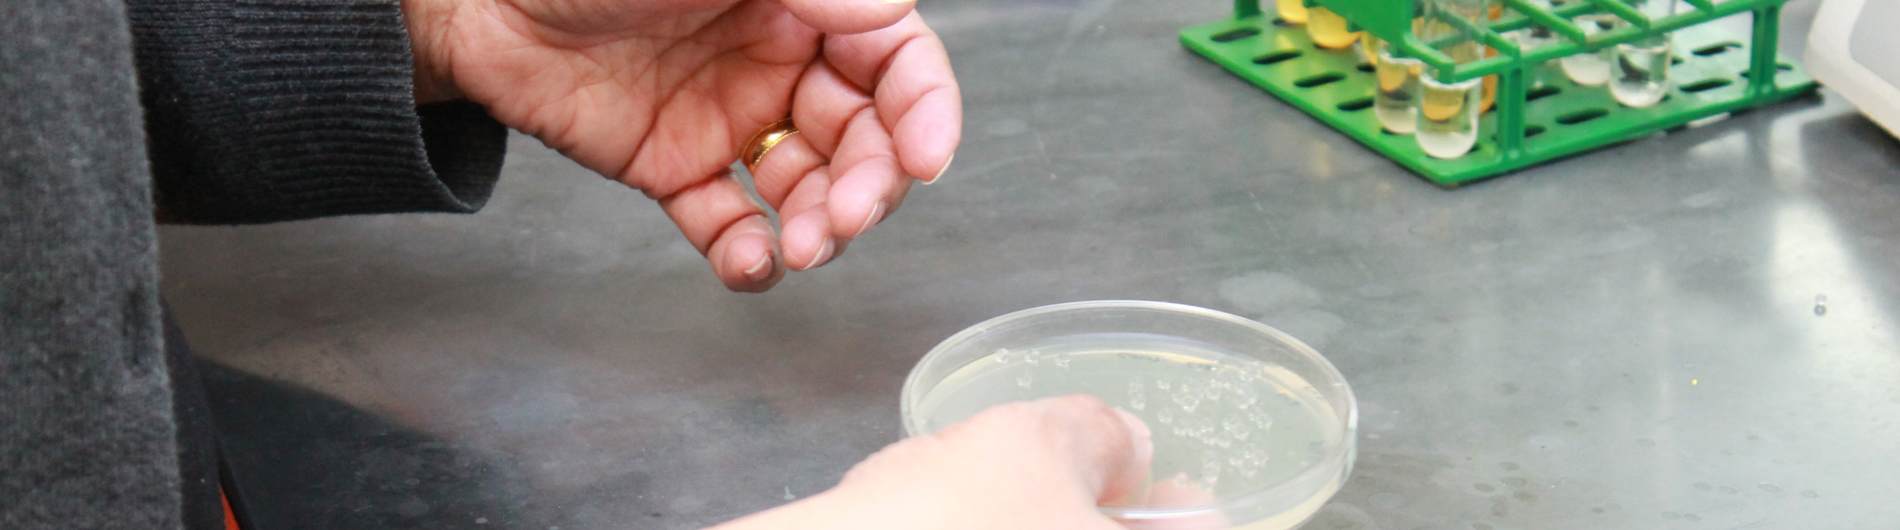
Dumont pic 6

Signal Transduction; Membrane Protein Structure, Yeast Molecular Biology
?Transmembrane proteins carry out critical functions in transporting ions and metabolites in an out of cells and organelles, in transducing extracellular signals into intracellular responses, in cell-cell recognition, and in catalyzing a variety of enzymatic reactions. They also constitute 20-30% of the protein coding potential of most genomes. However, the structures and molecular mechanisms of the function of membrane proteins remain much more poorly characterized than is the case for most soluble proteins. The Dumont laboratory focuses on understanding mechanisms of membrane protein function at the molecular level, often using yeast as a model system. We have developed procedures for expressing diverse membrane proteins in yeast and purifying them for structure determination by x-ray crystallography.
?Transmembrane proteins carry out critical functions in transporting ions and metabolites in an out of cells and organelles, in transducing extracellular signals into intracellular responses, in cell-cell recognition, and in catalyzing a variety of enzymatic reactions. They also constitute 20-30% of the protein coding potential of most genomes. However, the structures and molecular mechanisms of the function of membrane proteins remain much more poorly characterized than is the case for most soluble proteins. The Dumont laboratory focuses on understanding mechanisms of membrane protein function at the molecular level, often using yeast as a model system. We have developed procedures for expressing diverse membrane proteins in yeast and purifying them for structure determination by x-ray crystallography.
Members of the laboratory are also using genetic and biophysical approaches to understand mechanisms of signaling by the important class of G protein coupled receptors that are responsible for a wide variety of responses to hormones, neurotransmitters, and sensory stimuli. An additional project in the laboratory is the expression of the envelope glycoprotein from the HIV virus at the surface of yeast cells so that genetic approaches can be used to identify variant forms of the protein that will be useful for vaccine development.

Mark E. Dumont, Ph.D.
Principal Investigator
- Comparison of Experimental Approaches Used to Determine the Structure and Function of the Class D G Protein-Coupled Yeast α-Factor Receptor.; Biomolecules; Vol 12(6). 2022 May 30.
- Oligomerization of Yeast α-factor Receptor Detected by Fluorescent Energy Transfer Between Ligands.; Biophysical journal. 2021 Oct 07.
- Identification of variant HIV envelope proteins with enhanced affinities for precursors to anti-gp41 broadly neutralizing antibodies.; PloS one; Vol 14(9). 2019.
- Display of the HIV envelope protein at the yeast cell surface for immunogen development.; PloS one; Vol 13(10). 2018.
News
Affiliations
November 6, 2018
Dumont Receives 2018 Outstanding Graduate Student Teacher Award
August 28, 2017
Dumont Selected as the 2017 Recipient of the Graduate Student Society Advocacy Award
July 31, 2014
Department of Biochemistry and Biophysics Celebrates 15-Year Service Awards
June 15, 2013
Using Yeast to Unravel Premature Aging Disorder
Contact Us
Dumont Lab
MC 3-7518
601 Elmwood Ave
Rochester, NY 14642